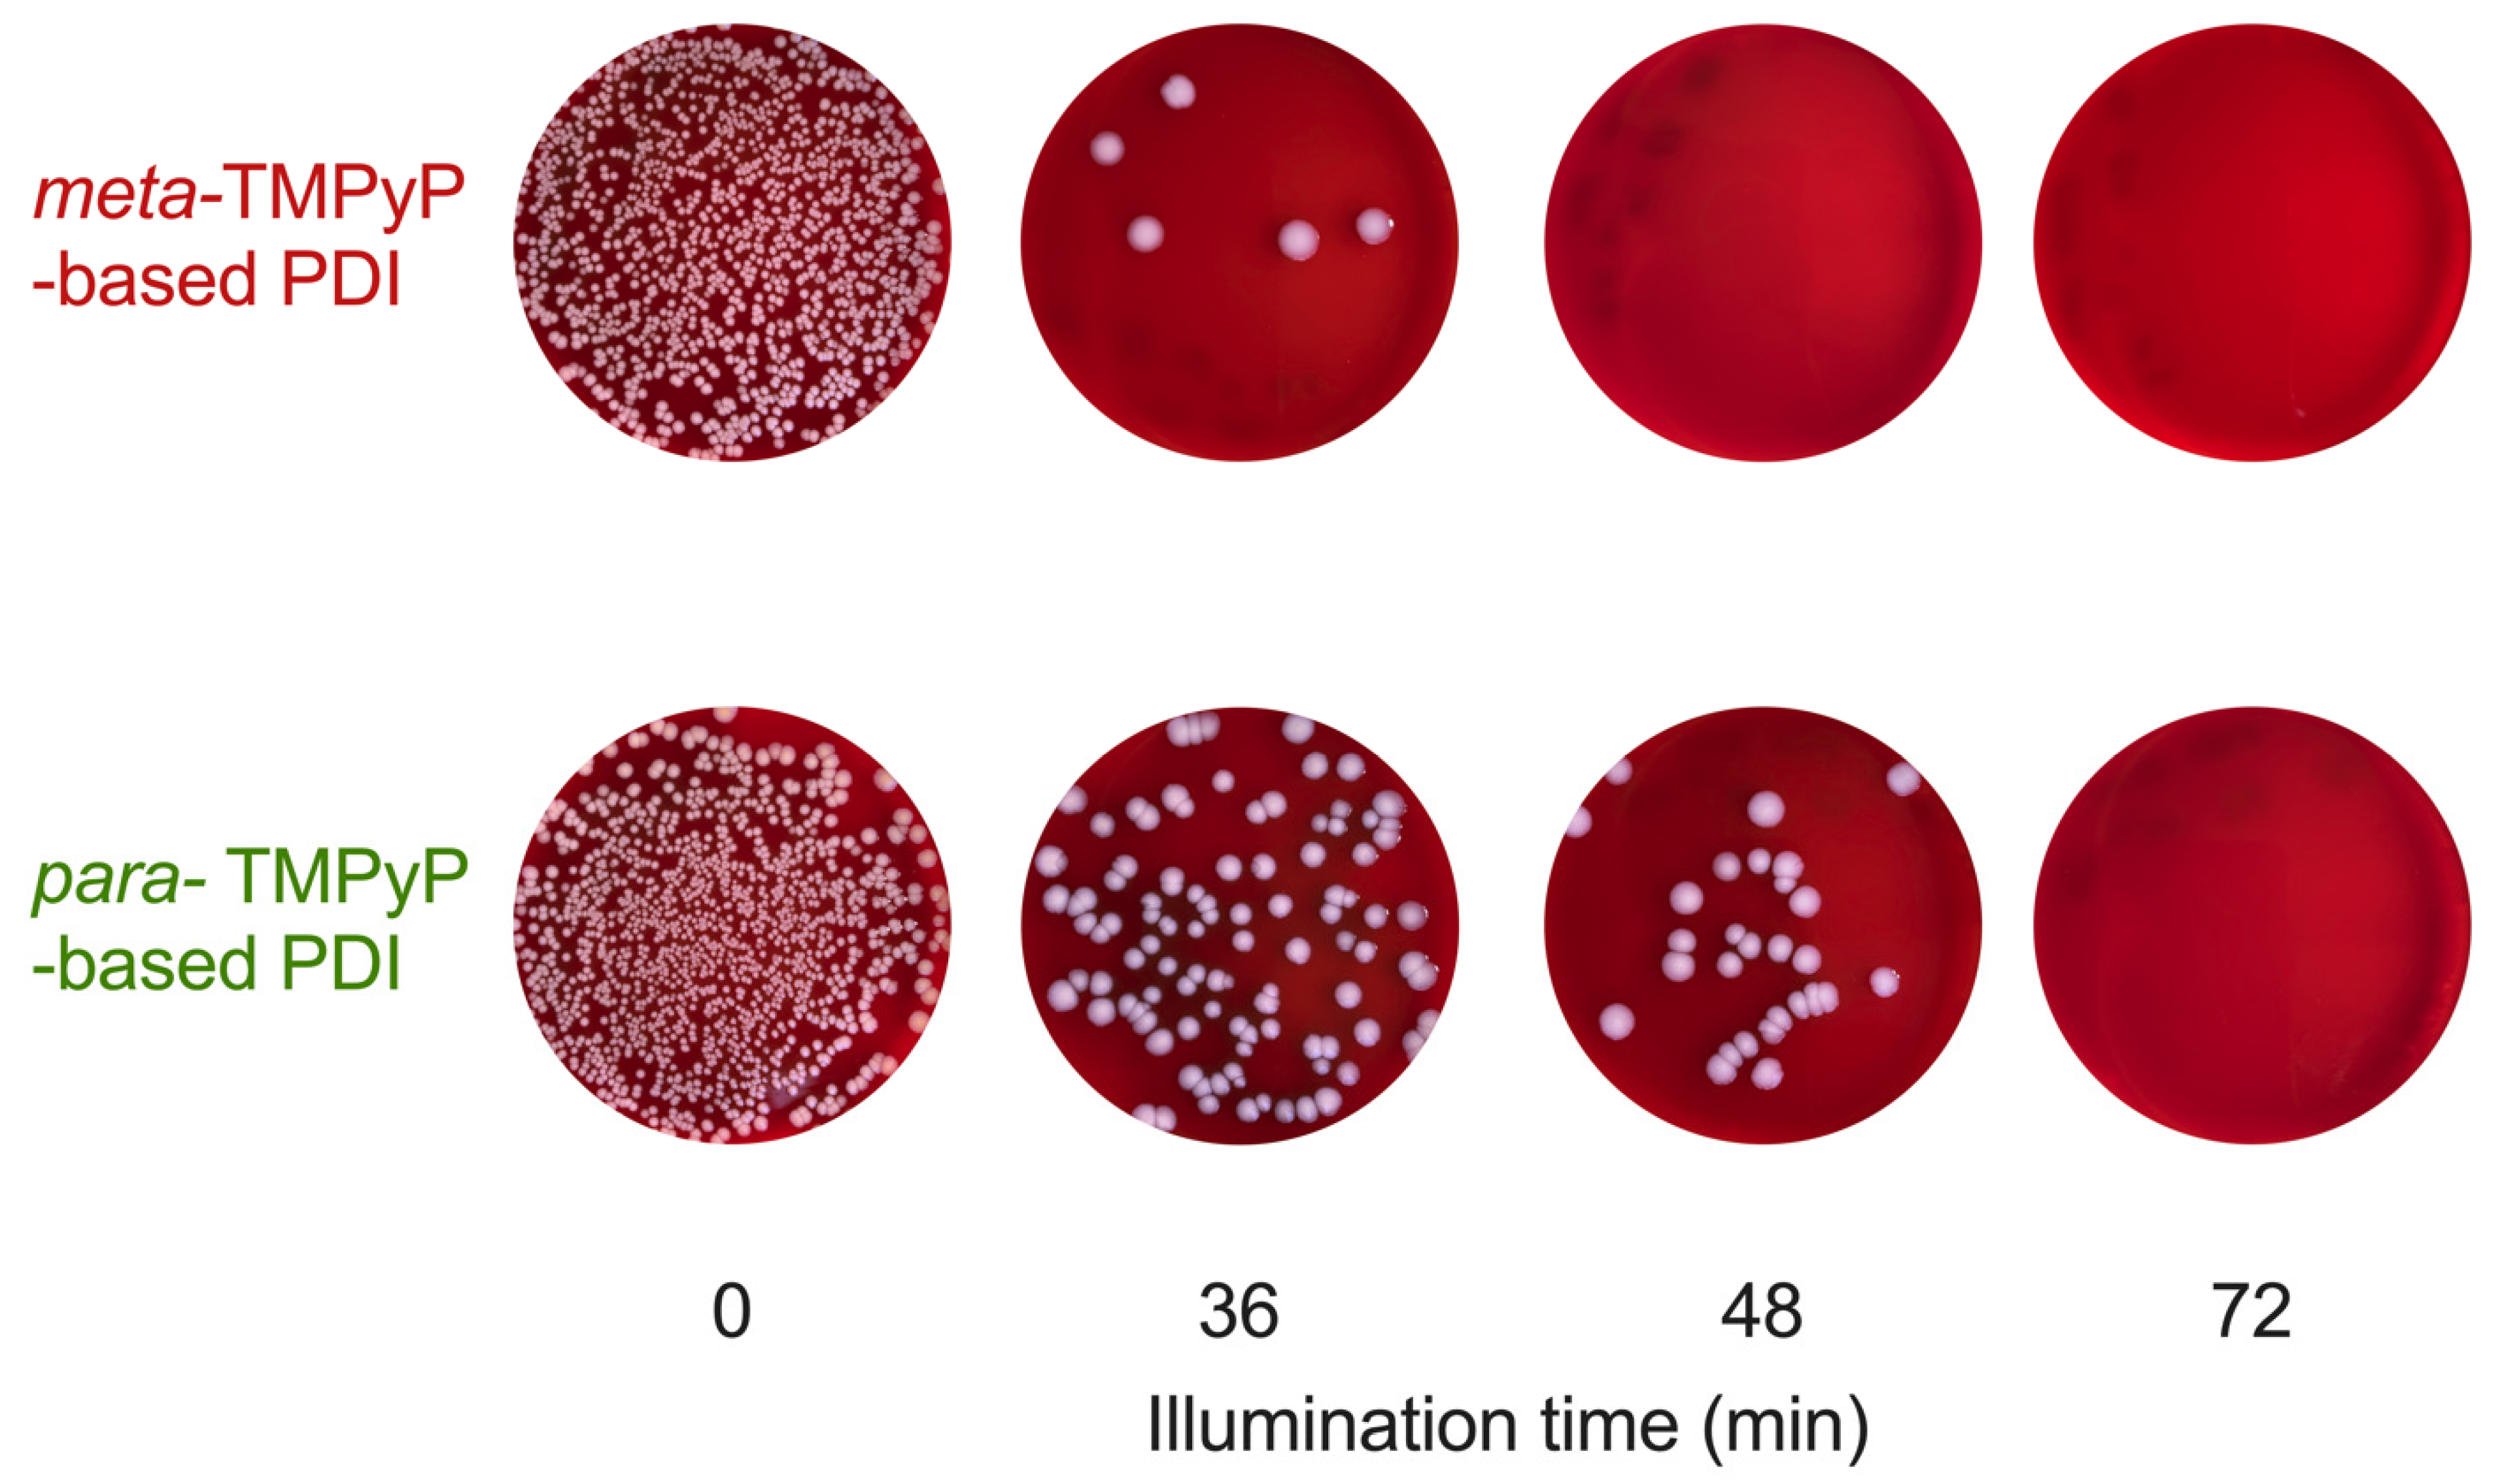
Microorganisms 10 00858 g005

The Meta-Substituted Isomer of TMPyP Enables More Effective Photodynamic Bacterial Inactivation than Para-TMPyP In Vitro
Abstract
:1. Introduction
2. Materials and Methods
2.1. Synthesis of Photosensitizers
2.2. Compound Analysis
2.3. Bacterial Strains
2.4. Photosensitizers
2.5. Photodynamic Inactivation Procedure
2.6. Detection of Singlet Oxygen
2.7. Statistical Analysis
3. Results
3.1. Synthesis Results
3.2. Single Crystal X-ray Crystallographic Diffraction Study
3.3. UV–VIS Analysis
3.4. Photostability
3.5. Generation of Singlet Oxygen
3.6. Photodynamic Experiments
4. Discussion
Limitations
5. Conclusions
Supplementary Materials
Author Contributions
Funding
Institutional Review Board Statement
Informed Consent Statement
Data Availability Statement
Acknowledgments
Conflicts of Interest
References
- Ferri, M.; Ranucci, E.; Romagnoli, P.; Giaccone, V. Antimicrobial Resistance: A Global Emerging Threat to Public Health Systems. Crit. Rev. Food Sci. Nutr. 2017, 57, 2857–2876. [Google Scholar] [CrossRef]
- Christaki, E.; Marcou, M.; Tofarides, A. Antimicrobial Resistance in Bacteria: Mechanisms, Evolution, and Persistence. J. Mol. Evol. 2020, 88, 26–40. [Google Scholar] [CrossRef] [PubMed]
- De Oliveira, D.M.P.; Forde, B.M.; Kidd, T.J.; Harris, P.N.A.; Schembri, M.A.; Beatson, S.A.; Paterson, D.L.; Walker, M.J. Antimicrobial Resistance in ESKAPE Pathogens. Clin. Microbiol. Rev. 2020, 33, e00181-19. [Google Scholar] [CrossRef] [PubMed]
- Høiby, N.; Bjarnsholt, T.; Givskov, M.; Molin, S.; Ciofu, O. Antibiotic Resistance of Bacterial Biofilms. Int. J. Antimicrob. Agents 2010, 35, 322–332. [Google Scholar] [CrossRef] [Green Version]
- McEwen, S.A.; Collignon, P.J. Antimicrobial Resistance: A One Health Perspective. Microbiol. Spectr. 2018, 6, 1–26. [Google Scholar] [CrossRef] [Green Version]
- Vincent, J.-L.; Rello, J.; Marshall, J.; Silva, E.; Anzueto, A.; Martin, C.D.; Moreno, R.; Lipman, J.; Gomersall, C.; Sakr, Y.; et al. International Study of the Prevalence and Outcomes of Infection in Intensive Care Units. JAMA 2009, 302, 2323–2329. [Google Scholar] [CrossRef] [Green Version]
- Antimicrobial Resistance Collaborators Global Burden of Bacterial Antimicrobial Resistance in 2019: A Systematic Analysis. Lancet 2022, 399, 629–655. [CrossRef]
- de Kraker, M.E.A.; Stewardson, A.J.; Harbarth, S. Will 10 Million People Die a Year Due to Antimicrobial Resistance by 2050? PLoS Med. 2016, 13, e1002184. [Google Scholar] [CrossRef] [Green Version]
- Bassetti, M.; Righi, E.; Vena, A.; Graziano, E.; Russo, A.; Peghin, M. Risk Stratification and Treatment of ICU-Acquired Pneumonia Caused by Multidrug- Resistant/Extensively Drug-Resistant/Pandrug-Resistant Bacteria. Curr. Opin. Crit. Care 2018, 24, 385–393. [Google Scholar] [CrossRef]
- Bassetti, M.; Poulakou, G.; Timsit, J.-F. Focus on Antimicrobial Use in the Era of Increasing Antimicrobial Resistance in ICU. Intensive Care Med. 2016, 42, 955–958. [Google Scholar] [CrossRef] [Green Version]
- de Kraker, M.E.A.; Davey, P.G.; Grundmann, H.; BURDEN study group. Mortality and Hospital Stay Associated with Resistant Staphylococcus Aureus and Escherichia Coli Bacteremia: Estimating the Burden of Antibiotic Resistance in Europe. PLoS Med. 2011, 8, e1001104. [Google Scholar] [CrossRef] [PubMed] [Green Version]
- Walsh, C. Where Will New Antibiotics Come From? Nat. Rev. Microbiol. 2003, 1, 65–70. [Google Scholar] [CrossRef] [PubMed]
- Fischbach, M.A.; Walsh, C.T. Antibiotics for Emerging Pathogens. Science 2009, 325, 1089–1093. [Google Scholar] [CrossRef] [PubMed]
- Agostinis, P.; Berg, K.; Cengel, K.A.; Foster, T.H.; Girotti, A.W.; Gollnick, S.O.; Hahn, S.M.; Hamblin, M.R.; Juzeniene, A.; Kessel, D.; et al. Photodynamic Therapy of Cancer: An Update. CA Cancer J. Clin. 2011, 61, 250–281. [Google Scholar] [CrossRef] [PubMed]
- Hamblin, M.R. Antimicrobial Photodynamic Inactivation: A Bright New Technique to Kill Resistant Microbes. Curr. Opin. Microbiol. 2016, 33, 67–73. [Google Scholar] [CrossRef] [Green Version]
- Wainwright, M.; Maisch, T.; Nonell, S.; Plaetzer, K.; Almeida, A.; Tegos, G.P.; Hamblin, M.R. Photoantimicrobials-Are We Afraid of the Light? Lancet Infect. Dis. 2017, 17, e49–e55. [Google Scholar] [CrossRef]
- Almeida, A. Photodynamic Therapy in the Inactivation of Microorganisms. Antibiotics 2020, 9, 138. [Google Scholar] [CrossRef] [Green Version]
- Almeida, A.; Faustino, M.A.F.; Tomé, J.P.C. Photodynamic Inactivation of Bacteria: Finding the Effective Targets. Future Med. Chem. 2015, 7, 1221–1224. [Google Scholar] [CrossRef]
- Ormond, A.B.; Freeman, H.S. Dye Sensitizers for Photodynamic Therapy. Materials 2013, 6, 817–840. [Google Scholar] [CrossRef] [Green Version]
- Dai, T.; Fuchs, B.B.; Coleman, J.J.; Prates, R.A.; Astrakas, C.; St Denis, T.G.; Ribeiro, M.S.; Mylonakis, E.; Hamblin, M.R.; Tegos, G.P. Concepts and Principles of Photodynamic Therapy as an Alternative Antifungal Discovery Platform. Front. Microbiol. 2012, 3, 120. [Google Scholar] [CrossRef] [Green Version]
- Abrahamse, H.; Hamblin, M.R. New Photosensitizers for Photodynamic Therapy. Biochem. J. 2016, 473, 347–364. [Google Scholar] [CrossRef] [PubMed] [Green Version]
- Gao, Y.; Mai, B.; Wang, A.; Li, M.; Wang, X.; Zhang, K.; Liu, Q.; Wei, S.; Wang, P. Antimicrobial Properties of a New Type of Photosensitizer Derived from Phthalocyanine against Planktonic and Biofilm Forms of Staphylococcus Aureus. Photodiagnosis Photodyn. Ther. 2018, 21, 316–326. [Google Scholar] [CrossRef]
- Imlay, J.A. Pathways of Oxidative Damage. Annu. Rev. Microbiol. 2003, 57, 395–418. [Google Scholar] [CrossRef] [PubMed]
- Martinez De Pinillos Bayona, A.; Mroz, P.; Thunshelle, C.; Hamblin, M.R. Design Features for Optimization of Tetrapyrrole Macrocycles as Antimicrobial and Anticancer Photosensitizers. Chem. Biol. Drug Des. 2017, 89, 192–206. [Google Scholar] [CrossRef] [PubMed] [Green Version]
- Maisch, T.; Bosl, C.; Szeimies, R.-M.; Lehn, N.; Abels, C. Photodynamic Effects of Novel XF Porphyrin Derivatives on Prokaryotic and Eukaryotic Cells. Antimicrob. Agents Chemother. 2005, 49, 1542–1552. [Google Scholar] [CrossRef] [Green Version]
- Simonetti, O.; Cirioni, O.; Orlando, F.; Alongi, C.; Lucarini, G.; Silvestri, C.; Zizzi, A.; Fantetti, L.; Roncucci, G.; Giacometti, A.; et al. Effectiveness of Antimicrobial Photodynamic Therapy with a Single Treatment of RLP068/Cl in an Experimental Model of Staphylococcus Aureus Wound Infection. Br. J. Dermatol. 2011, 164, 987–995. [Google Scholar] [CrossRef]
- Richter, M.F.; Drown, B.S.; Riley, A.P.; Garcia, A.; Shirai, T.; Svec, R.L.; Hergenrother, P.J. Predictive Compound Accumulation Rules Yield a Broad-Spectrum Antibiotic. Nature 2017, 545, 299–304. [Google Scholar] [CrossRef] [Green Version]
- Wang, J.; Wu, H.; Yang, Y.; Yan, R.; Zhao, Y.; Wang, Y.; Chen, A.; Shao, S.; Jiang, P.; Li, Y.-Q. Bacterial Species-Identifiable Magnetic Nanosystems for Early Sepsis Diagnosis and Extracorporeal Photodynamic Blood Disinfection. Nanoscale 2017, 10, 132–141. [Google Scholar] [CrossRef]
- Castano, A.P.; Demidova, T.N.; Hamblin, M.R. Mechanisms in Photodynamic Therapy: Part One-Photosensitizers, Photochemistry and Cellular Localization. Photodiagnosis Photodyn. Ther. 2004, 1, 279–293. [Google Scholar] [CrossRef] [Green Version]
- Nitzan, Y.; Dror, R.; Ladan, H.; Malik, Z.; Kimel, S.; Gottfried, V. Structure-Activity Relationship of Porphines for Photoinactivation of Bacteria. Photochem. Photobiol. 1995, 62, 342–347. [Google Scholar] [CrossRef]
- Cormick, M.P.; Quiroga, E.D.; Bertolotti, S.G.; Alvarez, M.G.; Durantini, E.N. Mechanistic Insight of the Photodynamic Effect Induced by Tri- and Tetra-Cationic Porphyrins on Candida Albicans Cells. Photochem. Photobiol. Sci. 2011, 10, 1556–1561. [Google Scholar] [CrossRef] [PubMed]
- Salmon-Divon, M.; Nitzan, Y.; Malik, Z. Mechanistic Aspects of Escherichia Coli Photodynamic Inactivation by Cationic Tetra-Meso(N-Methylpyridyl)Porphine. Photochem. Photobiol. Sci. 2004, 3, 423–429. [Google Scholar] [CrossRef] [PubMed]
- Tavares, A.; Dias, S.R.S.; Carvalho, C.M.B.; Faustino, M.A.F.; Tomé, J.P.C.; Neves, M.G.P.M.S.; Tomé, A.C.; Cavaleiro, J.A.S.; Cunha, Â.; Gomes, N.C.M.; et al. Mechanisms of Photodynamic Inactivation of a Gram-Negative Recombinant Bioluminescent Bacterium by Cationic Porphyrins. Photochem. Photobiol. Sci. 2011, 10, 1659–1669. [Google Scholar] [CrossRef]
- Zhao, Z.-J.; Xu, Z.-P.; Ma, Y.-Y.; Ma, J.-D.; Hong, G. Photodynamic Antimicrobial Chemotherapy in Mice with Pseudomonas Aeruginosa-Infected Wounds. PLoS ONE 2020, 15, e0237851. [Google Scholar] [CrossRef] [PubMed]
- Almeida, P.P.; Pereira, Í.S.; Rodrigues, K.B.; Leal, L.S.; Marques, A.S.; Rosa, L.P.; da Silva, F.C.; da Silva, R.A.A. Photodynamic Therapy Controls of Staphylococcus Aureus Intradermal Infection in Mice. Lasers Med. Sci. 2017, 32, 1337–1342. [Google Scholar] [CrossRef]
- Branco, T.M.; Valério, N.C.; Jesus, V.I.R.; Dias, C.J.; Neves, M.G.P.M.S.; Faustino, M.A.F.; Almeida, A. Single and Combined Effects of Photodynamic Therapy and Antibiotics to Inactivate Staphylococcus Aureus on Skin. Photodiagnosis Photodyn. Ther. 2018, 21, 285–293. [Google Scholar] [CrossRef]
- Lang, H.; Rueffer, T. Porphyrinoids Used for Photodynamic Inactivation against Bacteria. In Applications of Porphyrinoids as Functional Materials; Royal Society of Chemistry: London, UK, 2021; p. 352. ISBN 978-1-83916-188-9. [Google Scholar]
- Pereira, M.A.; Faustino, M.A.F.; Tomé, J.P.C.; Neves, M.G.P.M.S.; Tomé, A.C.; Cavaleiro, J.A.S.; Cunha, Â.; Almeida, A. Influence of External Bacterial Structures on the Efficiency of Photodynamic Inactivation by a Cationic Porphyrin. Photochem. Photobiol. Sci. 2014, 13, 680–690. [Google Scholar] [CrossRef]
- Maisch, T.; Spannberger, F.; Regensburger, J.; Felgenträger, A.; Bäumler, W. Fast and Effective: Intense Pulse Light Photodynamic Inactivation of Bacteria. J. Ind. Microbiol. Biotechnol. 2012, 39, 1013–1021. [Google Scholar] [CrossRef]
- Alves, E.; Costa, L.; Carvalho, C.M.B.; Tomé, J.P.C.; Faustino, M.A.; Neves, M.G.P.M.S.; Tomé, A.C.; Cavaleiro, J.A.S.; Cunha, A.; Almeida, A. Charge Effect on the Photoinactivation of Gram-Negative and Gram-Positive Bacteria by Cationic Meso-Substituted Porphyrins. BMC Microbiol. 2009, 9, 70. [Google Scholar] [CrossRef] [Green Version]
- Ladeira, B.M.F.; Dias, C.J.; Gomes, A.T.P.C.; Tomé, A.C.; Neves, M.G.P.M.S.; Moura, N.M.M.; Almeida, A.; Faustino, M.A.F. Cationic Pyrrolidine/Pyrroline-Substituted Porphyrins as Efficient Photosensitizers against E. coli. Molecules 2021, 26, 464. [Google Scholar] [CrossRef]
- Ash, C.; Dubec, M.; Donne, K.; Bashford, T. Effect of Wavelength and Beam Width on Penetration in Light-Tissue Interaction Using Computational Methods. Lasers Med. Sci. 2017, 32, 1909–1918. [Google Scholar] [CrossRef] [PubMed]
- Plaetzer, K.; Krammer, B.; Berlanda, J.; Berr, F.; Kiesslich, T. Photophysics and Photochemistry of Photodynamic Therapy: Fundamental Aspects. Lasers Med. Sci. 2009, 24, 259–268. [Google Scholar] [CrossRef] [PubMed]
- Glass, S.; Rüdiger, T.; Griebel, J.; Abel, B.; Schulze, A. Uptake and Release of Photosensitizers in a Hydrogel for Applications in Photodynamic Therapy: The Impact of Structural Parameters on Intrapolymer Transport Dynamics. RSC Adv. 2018, 8, 41624–41632. [Google Scholar] [CrossRef] [Green Version]
- Glass, S.; Kühnert, M.; Lippmann, N.; Zimmer, J.; Werdehausen, R.; Abel, B.; Eulenburg, V.; Schulze, A. Photosensitizer-Loaded Hydrogels for Photodynamic Inactivation of Multirestistant Bacteria in Wounds. RSC Adv. 2021, 11, 7600–7609. [Google Scholar] [CrossRef]
- Ricatto, L.G.O.; Conrado, L.A.L.; Turssi, C.P.; França, F.M.G.; Basting, R.T.; Amaral, F.L.B. Comparative Evaluation of Photodynamic Therapy Using LASER or Light Emitting Diode on Cariogenic Bacteria: An in Vitro Study. Eur. J. Dent. 2014, 8, 509–514. [Google Scholar] [CrossRef]
- Ziganshyna, S.; Guttenberger, A.; Lippmann, N.; Schulz, S.; Bercker, S.; Kahnt, A.; Rüffer, T.; Voigt, A.; Gerlach, K.; Werdehausen, R. Tetrahydroporphyrin-Tetratosylate (THPTS)-Based Photodynamic Inactivation of Critical Multidrug-Resistant Bacteria in Vitro. Int. J. Antimicrob. Agents 2020, 55, 105976. [Google Scholar] [CrossRef]
- Lang, H.; Rueffer, T. Porphyrinoids for Photodynamic Therapy. In Applications of Porphyrinoids as Functional Materials; Royal Society of Chemistry: London, UK, 2021; pp. 252–291. ISBN 978-1-83916-415-6. [Google Scholar]
- Riyad, Y.M.; Naumov, S.; Schastak, S.; Griebel, J.; Kahnt, A.; Häupl, T.; Neuhaus, J.; Abel, B.; Hermann, R. Chemical Modification of a Tetrapyrrole-Type Photosensitizer: Tuning Application and Photochemical Action beyond the Singlet Oxygen Channel. J. Phys. Chem. B 2014, 118, 11646–11658. [Google Scholar] [CrossRef]
- Dabrowski, J.M.; Arnaut, L.G.; Pereira, M.M.; Monteiro, C.J.P.; Urbańska, K.; Simões, S.; Stochel, G. New Halogenated Water-Soluble Chlorin and Bacteriochlorin as Photostable PDT Sensitizers: Synthesis, Spectroscopy, Photophysics, and in Vitro Photosensitizing Efficacy. ChemMedChem 2010, 5, 1770–1780. [Google Scholar] [CrossRef]
- Dąbrowski, J.M.; Pucelik, B.; Pereira, M.M.; Arnaut, L.G.; Stochel, G. Towards Tuning PDT Relevant Photosensitizer Properties: Comparative Study for the Free and Zn2+ Coordinated Meso-Tetrakis[2,6-Difluoro-5-(N-Methylsulfamylo)Phenyl]Porphyrin. J. Coord. Chem. 2015, 68, 3116–3134. [Google Scholar] [CrossRef]
- Sułek, A.; Pucelik, B.; Kobielusz, M.; Barzowska, A.; Dąbrowski, J.M. Photodynamic Inactivation of Bacteria with Porphyrin Derivatives: Effect of Charge, Lipophilicity, ROS Generation, and Cellular Uptake on Their Biological Activity In Vitro. Int. J. Mol. Sci. 2020, 21, 8716. [Google Scholar] [CrossRef]
- Supur, M.; Fukuzumi, S. Photodriven Electron Transport within the Columnar Perylenediimide Nanostructures Self-Assembled with Sulfonated Porphyrins in Water. J. Phys. Chem. C 2012, 116, 23274–23282. [Google Scholar] [CrossRef]
- Sułek, A.; Pucelik, B.; Kuncewicz, J.; Dubin, G.; Dąbrowski, J.M. Sensitization of TiO2 by Halogenated Porphyrin Derivatives for Visible Light Biomedical and Environmental Photocatalysis. Catal. Today 2019, 335, 538–549. [Google Scholar] [CrossRef]
- Fiel, R.J.; Datta-Gupta, N.; Mark, E.H.; Howard, J.C. Induction of DNA Damage by Porphyrin Photosensitizers. Cancer Res. 1981, 41, 3543–3545. [Google Scholar] [PubMed]
- Muehler, D.; Brandl, E.; Hiller, K.-A.; Cieplik, F.; Maisch, T. Membrane Damage as Mechanism of Photodynamic Inactivation Using Methylene Blue and TMPyP in Escherichia Coli and Staphylococcus Aureus. Photochem. Photobiol. Sci. 2022, 21, 209–220. [Google Scholar] [CrossRef] [PubMed]
- Eckl, D.B.; Dengler, L.; Nemmert, M.; Eichner, A.; Bäumler, W.; Huber, H. A Closer Look at Dark Toxicity of the Photosensitizer TMPyP in Bacteria. Photochem. Photobiol. 2018, 94, 165–172. [Google Scholar] [CrossRef] [Green Version]
- Kalyanasundaram, K. Photochemistry of Water-Soluble Porphyrins: Comparative Study of Isomeric Tetrapyridyl- and Tetrakis(N-Methylpyridiniumyl)Porphyrins. Inorg. Chem. 1984, 23, 2453–2459. [Google Scholar] [CrossRef]
- Sheldrick, G.M. A Short History of SHELX. Acta Crystallogr. A 2008, 64, 112–122. [Google Scholar] [CrossRef] [Green Version]
- Habermann, N.; Wachs, M.; Schulz, S.; Werdehausen, R.; Schwarz, U.T. Development and Characterization of Planar LED Arrays for Medical Applications. Jpn. J. Appl. Phys. 2019, 58, SCCC25. [Google Scholar] [CrossRef]
- Seidel, R.W.; Goddard, R.; Hoch, C.; Breidung, J.; Oppel, I.M. On the Structure of Unsolvated Free-Base 5,10,15,20-Tetra(3-Pyridyl)Porphyrin. J. Mol. Struct. 2011, 985, 307–315. [Google Scholar] [CrossRef]
- Jentzen, W.; Song, X.-Z.; Shelnutt, J.A. Structural Characterization of Synthetic and Protein-Bound Porphyrins in Terms of the Lowest-Frequency Normal Coordinates of the Macrocycle. J. Phys. Chem. B 1997, 101, 1684–1699. [Google Scholar] [CrossRef]
- Artur, T.; Snow, W. Phthalocyanines: Properties and Materials. In The Porphyrin Handbook; Academic Press: Cambridge, MA, USA, 2003. [Google Scholar]
- Sobbi, A.K.; Wöhrle, D.; Schlettwein, D. Photochemical Stability of Various Porphyrins in Solution and as Thin Film Electrodes. J. Chem. Soc. Perkin Trans. 2 1993, 3, 481–488. [Google Scholar] [CrossRef]
- Menezes, P.F.C.; Imasato, H.; Ferreira, J.; Bagnato, V.S.; Sibata, C.H.; Perussi, J.R. Aggregation Susceptibility on Phototransformation of Hematoporphyrin Derivatives. Laser Phys. Lett. 2007, 5, 227. [Google Scholar] [CrossRef]
- Cavaleiro, J.A.S.; Görner, H.; Lacerda, P.S.S.; MacDonald, J.G.; Mark, G.; Neves, M.G.P.M.S.; Nohr, R.S.; Schuchmann, H.-P.; von Sonntag, C.; Tomé, A.C. Singlet Oxygen Formation and Photostability of Meso-Tetraarylporphyrin Derivatives and Their Copper Complexes. J. Photochem. Photobiol. A Chem. 2001, 144, 131–140. [Google Scholar] [CrossRef]
- Sobotta, L.; Skupin-Mrugalska, P.; Piskorz, J.; Mielcarek, J. Porphyrinoid Photosensitizers Mediated Photodynamic Inactivation against Bacteria. Eur. J. Med. Chem. 2019, 175, 72–106. [Google Scholar] [CrossRef] [PubMed]
- Kalyanasundaram, K.; Neumann-Spallart, M. Photophysical and Redox Properties of Water-Soluble Porphyrins in Aqueous Media. J. Phys. Chem. 1982, 86, 5163–5169. [Google Scholar] [CrossRef]
- Berezina, N.M.; Berezin, M.B.; Semeikin, A.S. Solvation Interactions and Photostability of Tetrakis(1-Methylpyridyl)Porphyrin Derivatives. J. Mol. Liq. 2019, 290, 111196. [Google Scholar] [CrossRef]
- Ford, K.G.; Pearl, L.H.; Neidle, S. Molecular Modelling of the Interactions of Tetra-(4-N-Methylpyridyl) Porphin with TA and CG Sites on DNA. Nucleic Acids Res. 1987, 15, 6553–6562. [Google Scholar] [CrossRef]
- Huang, L.; Krayer, M.; Roubil, J.G.S.; Huang, Y.-Y.; Holten, D.; Lindsey, J.S.; Hamblin, M.R. Stable Synthetic Mono-Substituted Cationic Bacteriochlorins Mediate Selective Broad-Spectrum Photoinactivation of Drug-Resistant Pathogens at Nanomolar Concentrations. J. Photochem. Photobiol. B 2014, 141, 119–127. [Google Scholar] [CrossRef] [Green Version]
- Oliveira, C.S.; Turchiello, R.; Kowaltowski, A.J.; Indig, G.L.; Baptista, M.S. Major Determinants of Photoinduced Cell Death: Subcellular Localization versus Photosensitization Efficiency. Free Radic. Biol. Med. 2011, 51, 824–833. [Google Scholar] [CrossRef]
- Ezzeddine, R.; Al-Banaw, A.; Tovmasyan, A.; Craik, J.D.; Batinic-Haberle, I.; Benov, L.T. Effect of Molecular Characteristics on Cellular Uptake, Subcellular Localization, and Phototoxicity of Zn(II) N-Alkylpyridylporphyrins. J. Biol. Chem. 2013, 288, 36579–36588. [Google Scholar] [CrossRef] [Green Version]
- Costa, D.C.S.; Gomes, M.C.; Faustino, M.A.F.; Neves, M.G.P.M.S.; Cunha, Â.; Cavaleiro, J.A.S.; Almeida, A.; Tomé, J.P.C. Comparative Photodynamic Inactivation of Antibiotic Resistant Bacteria by First and Second Generation Cationic Photosensitizers. Photochem. Photobiol. Sci. 2012, 11, 1905–1913. [Google Scholar] [CrossRef] [PubMed]
- Dlugaszewska, J.; Szczolko, W.; Koczorowski, T.; Skupin-Mrugalska, P.; Teubert, A.; Konopka, K.; Kucinska, M.; Murias, M.; Düzgüneş, N.; Mielcarek, J.; et al. Antimicrobial and Anticancer Photodynamic Activity of a Phthalocyanine Photosensitizer with N-Methyl Morpholiniumethoxy Substituents in Non-Peripheral Positions. J. Inorg. Biochem. 2017, 172, 67–79. [Google Scholar] [CrossRef] [PubMed]
- McMillin, D.R.; Shelton, A.H.; Bejune, S.A.; Fanwick, P.E.; Wall, R.K. Understanding Binding Interactions of Cationic Porphyrins with B-Form DNA. Coord. Chem. Rev. 2005, 249, 1451–1459. [Google Scholar] [CrossRef]
- Mathew, D.; Sujatha, S. Interactions of Porphyrins with DNA: A Review Focusing Recent Advances in Chemical Modifications on Porphyrins as Artificial Nucleases. J. Inorg. Biochem. 2021, 219, 111434. [Google Scholar] [CrossRef] [PubMed]
- Engelmann, F.M.; Rocha, S.V.O.; Toma, H.E.; Araki, K.; Baptista, M.S. Determination of N-Octanol/Water Partition and Membrane Binding of Cationic Porphyrins. Int. J. Pharm. 2007, 329, 12–18. [Google Scholar] [CrossRef]
- Schneider, H.-J.; Wang, M. Supramolecular Chemistry. 49. Ligand-Porphyrin Complexes: Quantitative Evaluation of Stacking and Ionic Contributions. J. Org. Chem. 1994, 59, 7464–7472. [Google Scholar] [CrossRef]
- Pasternack, R.F.; Gibbs, E.J.; Gaudemer, A.; Antebi, A.; Bassner, S.; De Poy, L.; Turner, D.H.; Williams, A.; Laplace, F.; Lansard, M.H.; et al. Molecular Complexes of Nucleosides and Nucleotides with a Monomeric Cationic Porphyrin and Some of Its Metal Derivatives. J. Am. Chem. Soc. 1985, 107, 8179–8186. [Google Scholar] [CrossRef]
- Kano, K.; Fukuda, K.; Wakami, H.; Nishiyabu, R.; Pasternack, R.F. Factors Influencing Self-Aggregation Tendencies of Cationic Porphyrins in Aqueous Solution. J. Am. Chem. Soc. 2000, 122, 7494–7502. [Google Scholar] [CrossRef]

| B Band λ/nm | Q Bands λ/nm | ||||
|---|---|---|---|---|---|
| B(0,0) (lg ε) | QX(1,0) (lg ε) | QX(0,0) (lg ε) | Qy(1,0) (lg ε) | Qy(0,0) (lg ε) | |
| meta-TMPyP | 418 (5.48) | 515 (4.27) | 550 (3.59) | 583 (3.82) | 636 (2.94) |
| para-TMPyP | 422 (5.29) | 518 (4.12) | 556 (3.73) | 586 (3.78) | 643 (3.08) |
Publisher’s Note: MDPI stays neutral with regard to jurisdictional claims in published maps and institutional affiliations. |
© 2022 by the authors. Licensee MDPI, Basel, Switzerland. This article is an open access article distributed under the terms and conditions of the Creative Commons Attribution (CC BY) license (https://creativecommons.org/licenses/by/4.0/).
Share and Cite
Schulz, S.; Ziganshyna, S.; Lippmann, N.; Glass, S.; Eulenburg, V.; Habermann, N.; Schwarz, U.T.; Voigt, A.; Heilmann, C.; Rüffer, T.; et al. The Meta-Substituted Isomer of TMPyP Enables More Effective Photodynamic Bacterial Inactivation than Para-TMPyP In Vitro. Microorganisms 2022, 10, 858. https://doi.org/10.3390/microorganisms10050858
Schulz S, Ziganshyna S, Lippmann N, Glass S, Eulenburg V, Habermann N, Schwarz UT, Voigt A, Heilmann C, Rüffer T, et al. The Meta-Substituted Isomer of TMPyP Enables More Effective Photodynamic Bacterial Inactivation than Para-TMPyP In Vitro. Microorganisms. 2022; 10(5):858. https://doi.org/10.3390/microorganisms10050858
Chicago/Turabian StyleSchulz, Sebastian, Svitlana Ziganshyna, Norman Lippmann, Sarah Glass, Volker Eulenburg, Natalia Habermann, Ulrich T. Schwarz, Alexander Voigt, Claudia Heilmann, Tobias Rüffer, and et al. 2022. "The Meta-Substituted Isomer of TMPyP Enables More Effective Photodynamic Bacterial Inactivation than Para-TMPyP In Vitro" Microorganisms 10, no. 5: 858. https://doi.org/10.3390/microorganisms10050858
APA StyleSchulz, S., Ziganshyna, S., Lippmann, N., Glass, S., Eulenburg, V., Habermann, N., Schwarz, U. T., Voigt, A., Heilmann, C., Rüffer, T., & Werdehausen, R. (2022). The Meta-Substituted Isomer of TMPyP Enables More Effective Photodynamic Bacterial Inactivation than Para-TMPyP In Vitro. Microorganisms, 10(5), 858. https://doi.org/10.3390/microorganisms10050858

